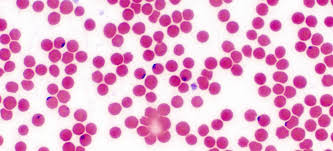

MyShockerHealth Newsletter • Issue 7 • June 23, 2026

Welcome to the myShockerHealth newsletter!
It is June, yes, I am behind getting a newsletter out this month! Are we busy at Student Health? You bet! Summertime brings new concerns and challenges; ticks and mosquitoes, skin care, outdoor recreation, severe weather, are just to name a few!
Links to the most current newsletter will be posted through WSU newsletters, social media, and our website, wichita.edu/shs. Enjoy!
For content requests: student.health@wichita.edu